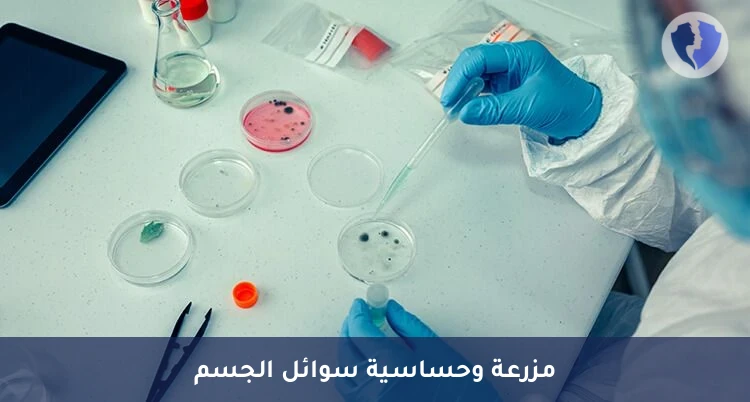
مزرعة سوائل الجسم المختلفة - مزرعة وحساسية سوائل الجسم

تفاصيل الخدمة
مزرعة سوائل الجسم المختلفة - مزرعة وحساسية سوائل الجسم
باقة تشخيصية متكاملة تشمل: أولاً، الفحص المجهري المباشر والزراعة (Culture) لعينة سائل الجسم المعقم (الرئوي، البريتوني، المفصلي، التاموري، إلخ) على أوساط مغذية ملائمة للكشف عن نمو البكتيريا أو الفطريات. ثانياً، اختبار الحساسية للمضادات الميكروبية (Susceptibility Testing) لأي كائن معزول لتحديد أنسب مضاد حيوي أو مضاد فطري للعلاق.